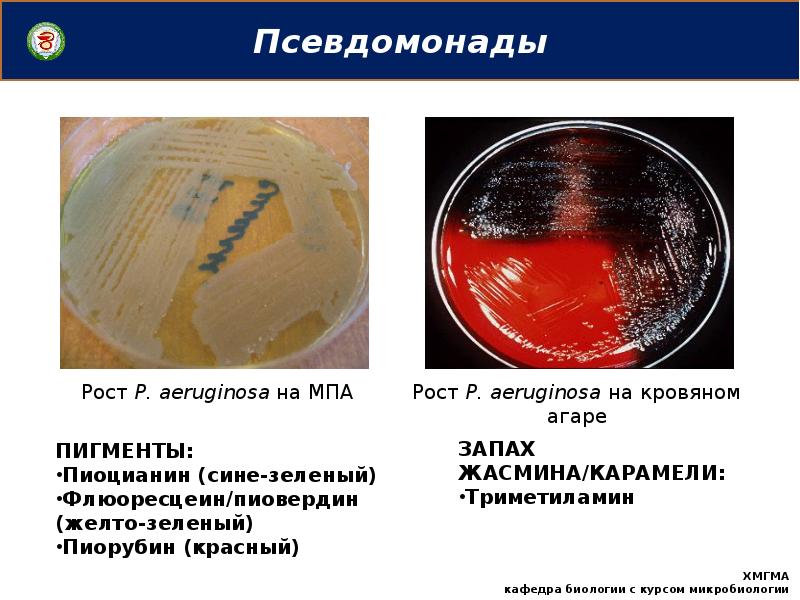
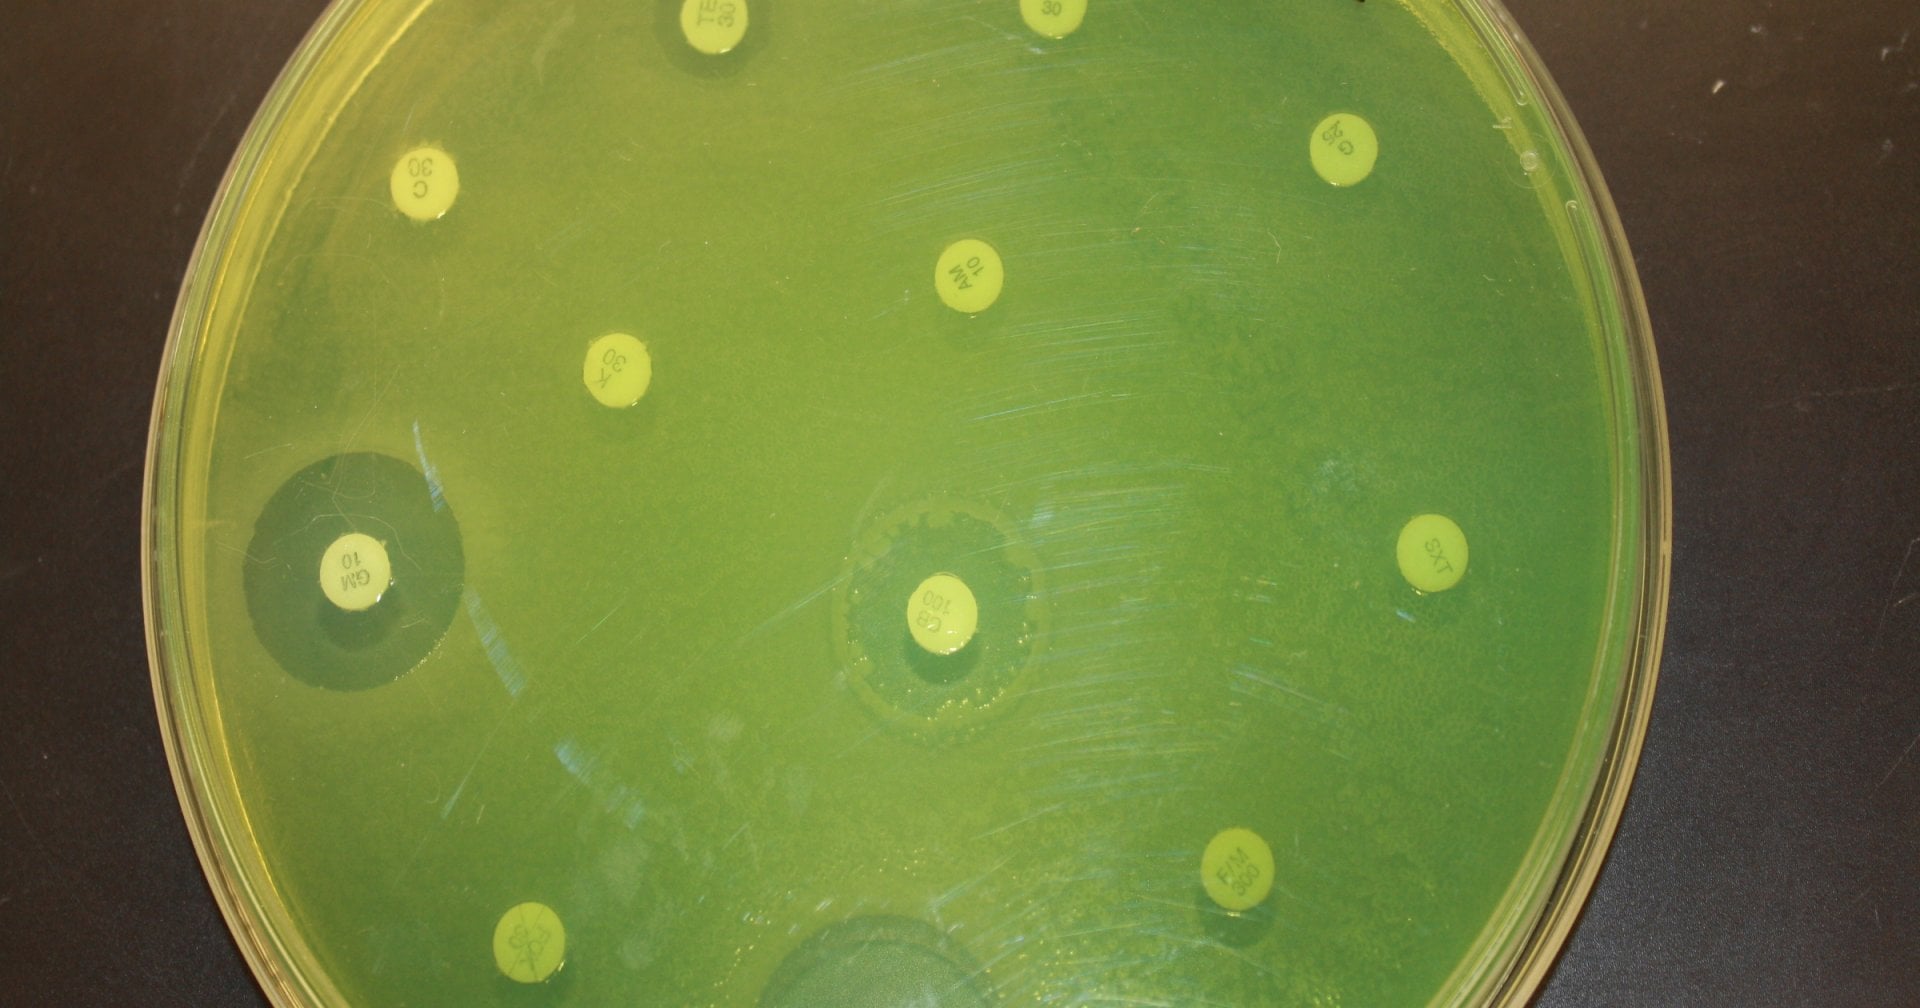

Цпх агар
Jeanette певица
Прямая трансляция тв канала стс
Функции философии исторические
Фермерская грядка
Ведение нэпа
Эбру шахин последние новости на сегодня 2025
Размер тетради а5 в сантиметрах
Радиатор маквин
Билайн координаты телефон
Почему пришло смс от заблокированного
Развитие философии политики
Будь добрым котиком
Вакансия помощник удаленная работа
Цпх агар 107 фотографий